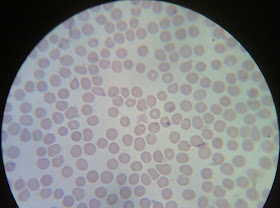

SEP DGETI SEMS
CENTRO DE BACHILLERATO TECNOLÓGICO
INDUSTRIAL Y DE SERVICIOS No. 199
“EMILIANO ZAPATA SALAZAR”
MIXQUIAHUALA, HGO.
REALIZAR BIOMETRÍA HEMÁTICA
PROFESOR: DR. VICENTE MARTÍNEZ FRAGOSO
ALUMNO: EDGAR URIEL RODRÍGUEZ MUÑOZ
GRADO: 4° SEMESTRE GRUPO: DM
ESPECIALIDAD: LABORATORISTA CLÍNICO
SEMESTRE: FEBRERO-JULIO 2012
PUNCIÓN CAPILAR
OBJETIVO
Aprender a realizar correctamente la obtención de sangre por punción capilar o cutánea.
FUNDAMENTO
Los vasos sanguíneos son los conductos que conducen la sangre, y se dividen en arterias, venas y capilares.
Los capilares son conductos sumamente delgados que se entrelazan formando redes entre las arterias y las venas. Están constituidas por una sola capa de células epiteliales planas (endotelio) que les permite ser muy permeables.
La punción capilar o cutánea recoge la sangre capilar que llega de las arteriolas, vénulas y capilares, mediante una microherida, en la epidermis, practicada con una aguja o lanceta. La composición de esta sangre es más parecida a la arterial que a la venosa.
Esta punción permite la obtención de una cantidad muy pequeña de sangre.
La sangre capilar se obtiene de la cara lateral del dedo medio o anular en los adultos, del lóbulo de la oreja y del dedo gordo del pie o talón en los niños.
MATERIAL:
v Algodón.
v Lancetas desechables y estériles
v Tubos capilares
v Portaobjetos
v Pipetas Pasteur
v Cuba de tinción
v Pizeta
SUSTANCIAS:
Ø Colorante de Wright
Ø Buffer de fosfato
Ø Alcohol al 70%
Ø Agua
PROCEDIMIENTO
1. Una vez seleccionada la zona, se desinfecta la zona con alcohol al 70%, secar con algodón estéril.
2. Punzar la piel con una lanceta estéril desechable (2 mm de profundidad).
3. La primera gota de sangre se deja perder, limpiándola con la gasa sin tocar la zona pinchada
4. Se espera a que caigan más gotas, sin exprimir el área pinchada porque eso diluiría la sangre con líquido extracelular. Se recogen las gotas de sangre necesarias sobre alguno de estos objetos:
ü La tira reactiva.
ü Tubo capilar, mientras se tapa su otro extremo con el dedo. Después de la recogida se pincha el tubo capilar en plastilina para que un pequeño fragmento de ésta obstruya su extremo o se sella con calor
ü Sobre un portaobjetos, si es necesario estudiar una extensión de sangre. En este caso, se recogio en un portaobjetos.
5. Aplicar tinción de Wright
OBSERVACIONES
![]() |
Frotis sanguíneo 10x Se observa la gran cantidad de eritrocitos que abundan en el frotis y en la sangre circulante. |
![]() |
Frotis 100x Diversos eritrocitos, con un neutrófilo en el centro del campo donde se puede distinguir con claridad su núcleo, y plaquetas conglomeradas en todo el campo |
![]() |
Frotis 100x Se distingue a las dos un codocito o célula en forma de blanco. A su lado izquierdo un linfocito, con su característico núcleo enorme y a las 9 un neutrófilo |
RESULTADOS
Como puede verse, es posible distinguir algunas de las células o elementos formes de la sangre, abundando en gran cantidad los eritrocitos, de los cuales la mayoría presentaba forma redonda con centro pálido, debido a su biconcavidad y otros más eran eliptocitos y solo fue encontrado un codocito como la forma más rara.
En cuanto a los leucocitos, abundaron los neutrófilos y unos cuantos linfocitos. No fue posible distinguir con claridad a los demás tipos de leucocitos, sin embargo esto no indica que no haya presencia de ellos en la sangre.
Las plaquetas, por lo regular se encontraban conglomeradas, presentándose como cuerpecillos diminutos color púrpura.
Debido a la falta de sangre, no fue posible llevar a cabo un micro hematocrito.
Pero cabe recordar que la finalidad de la práctica no es establecer todavía un diferencial, sino tomar la muestra correctamente.
CONCLUSIÓN
Los análisis sanguíneos son de gran importancia en el diagnóstico de muchas enfermedades, y son el pilar en los laboratorios clínicos. Dependiendo del tipo de examen a realizar o de las condiciones del paciente, es como se procederá a la toma de la muestra.
Se recurre a la punción capilar cuando la cantidad de sangre que se precisa es muy pequeña o cuando por diferentes motivos no pueda practicarse una punción venosa, por ejemplo en los recién nacidos, lactantes, niños donde no se observan adecuadamente las venas, en personas con quemaduras extensas o bien en pacientes que han recibido quimioterapia por cáncer y tienen sus venas fibrosas (duras).
Las ventajas que tiene la punción capilar son:
Ø Puede obtenerse con facilidad.
Ø Es preferible cuando han de realizarse extensiones de sangre periférica.
Y algunas de sus desventajas pueden ser:
Ø Sólo se pueden obtener pequeñas cantidades de sangre y los exámenes de repetición requieren nuevas muestras.
Ø La sangre en microtubos (capilares) frecuentemente se hemoliza interfiriendo con la mayoría de pruebas de laboratorio.
Ø Los resultados obtenidos en pruebas con sangre capilar no pueden ser comparados con los resultados de las pruebas con sangre venosa.
Ø El dedo no sólo es delicado sino difícil de desinfectar adecuadamente en el tiempo disponible.
Ø En pacientes con resistencia disminuida a la infección (aquellos con leucemia, agranulocitosis, diabetes, uremia y enfermedades con deficiencias inmunológicas), una muestra tomada del dedo es mucho más probable que conduzca a una infección que otra tomada del brazo.
Ø El recuento de eritrocitos y leucocitos, así como el recuento de plaquetas y Reticulocitos, no debe realizarse en sangre capilar debido a la difícil estandarización del flujo sanguíneo capilar.
Bibliografía:
· La técnica de punción capilar, documento en formato pdf, consultado el día 17 de febrero de 2012 en: http://www.enfervalencia.org/ei/80/articulos-cientificos/6.pdf
· Capítulo 6: obtención de muestras sanguíneas, articulo consultado en el manual electrónico de laboratorio clínico consultado el día viernes 17 de febrero de 2012 en: http://www.mailxmail.com/curso-laboratorio-obtencion-muestras/extraccion-sangre-capilar-1-2
· Higashida Hirose Bertha Yoshiko. Ciencias de la salud. McGraw-Hill, México, 1991. Pp. 173